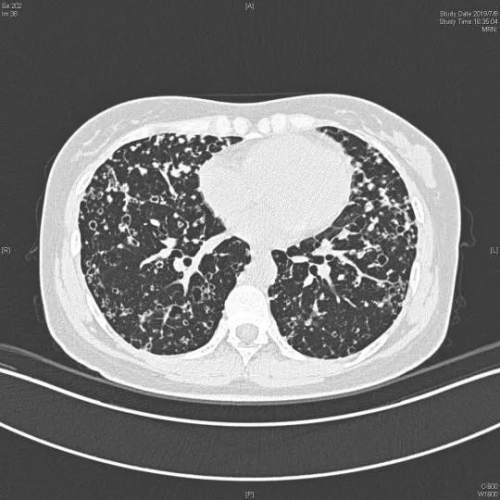

-
肺部數(shù)字醫(yī)學(xué)影像診斷取得新突破——西安工大“火眼金睛”團(tuán)隊(duì)創(chuàng)新圖像識(shí)別技術(shù)賦能胸部HRCT精準(zhǔn)診斷
2024/7/30 13:21:15 來源:中國產(chǎn)業(yè)發(fā)展研究網(wǎng) 【字體:大 中 小】【收藏本頁】【打印】【關(guān)閉】
核心提示:近日,由西安工業(yè)大學(xué)趙妙梅、趙何超團(tuán)隊(duì)主導(dǎo)的多學(xué)科交叉多專業(yè)融合的“火眼金睛”項(xiàng)目在數(shù)字醫(yī)學(xué)影像診斷領(lǐng)域取得重大進(jìn)展近日,由西安工業(yè)大學(xué)趙妙梅、趙何超團(tuán)隊(duì)主導(dǎo)的多學(xué)科交叉多專業(yè)融合的“火眼金睛”項(xiàng)目在數(shù)字醫(yī)學(xué)影像診斷領(lǐng)域取得重大進(jìn)展,該技術(shù)通過開發(fā)“CNN&Transformer”交錯(cuò)融合算法,成功賦能肺部數(shù)字醫(yī)學(xué)影像精準(zhǔn)診斷,為該行業(yè)提供創(chuàng)新解決方案。
調(diào)研發(fā)現(xiàn),肺部數(shù)字醫(yī)學(xué)影像診斷存在諸多痛點(diǎn),如:現(xiàn)有CT診斷系統(tǒng)多只能確定病灶位置,不能直接診斷病種,更不能預(yù)測(cè)病情;現(xiàn)階段雖出現(xiàn)AI醫(yī)生,但病人多表達(dá)“把胸片直接交給AI不放心”,希望以傳統(tǒng)方式由醫(yī)生親自閱片。然而近年來肺部疾病(肺結(jié)節(jié)、肺部感染等)持續(xù)高發(fā),其癥狀和影像學(xué)表現(xiàn)多不典型,早期就診率低,易漏診。
突破技術(shù)壁壘,打破資源瓶頸,創(chuàng)新解決方案
該團(tuán)隊(duì)科研攻關(guān)“空洞卷積神經(jīng)網(wǎng)絡(luò)(CNN)”技術(shù)和“動(dòng)態(tài)雙路徑多尺度特征融合(D-DMFF)”技術(shù),研發(fā)了可有效提取肺部HRCT圖像中的局部與全局特征的輕量化模型。該模型通過97740張CT圖像訓(xùn)練和5012張CT圖像的驗(yàn)證后,沒有明顯的過擬合或欠擬合現(xiàn)象,模型訓(xùn)練良好,病灶分辨率從原有的1mm提升至0.625mm,分辨力提升了37.5%,準(zhǔn)確率高達(dá)96.342%。具備低復(fù)雜度和高有效性,能夠更準(zhǔn)確的識(shí)別肺部病變CT圖像。


該項(xiàng)目在試驗(yàn)階段,從醫(yī)生肉眼漏診病人的上萬張HRCT圖像中,額外識(shí)別出100余人,有效降低了漏診率。
該項(xiàng)目目前已登記軟件著作權(quán)9項(xiàng)、授權(quán)發(fā)明專利2項(xiàng)、外觀設(shè)計(jì)專利1項(xiàng),SCI收錄論文2篇(中科院1篇)、EI收錄論文4篇。

該項(xiàng)目吸引了來自烏茲別克斯坦、塔吉克斯坦和加納國的留學(xué)生參與。近期正于國內(nèi)某大型數(shù)據(jù)云服務(wù)企業(yè)洽談合作,未來有望實(shí)現(xiàn)云端醫(yī)學(xué)影像診斷處理,為一帶一路沿線國家提供肺部醫(yī)學(xué)影像診斷中國方案。

鄭重聲明:本文版權(quán)歸原作者所有,轉(zhuǎn)載文章僅為傳播更多信息之目的,如有侵權(quán)行為,請(qǐng)第一時(shí)間聯(lián)系我們修改或刪除,多謝。
鄭重聲明:本文版權(quán)歸原作者所有,轉(zhuǎn)載文章僅為傳播更多信息之目的,如有侵權(quán)行為,請(qǐng)第一時(shí)間聯(lián)系我們修改或刪除,郵箱:cidr@chinaidr.com。 -
- 熱點(diǎn)資訊
- 24小時(shí)
- 周排行
- 月排行
- 前10月規(guī)上輕工企業(yè)實(shí)現(xiàn)營收19萬億元 同比增長1.9%
- “觀賽+滑雪+度假” 成新寵 冰雪賽事撬動(dòng)文旅消費(fèi)爆發(fā)式增長
- 職業(yè)更新打開高質(zhì)量就業(yè)新空間 為未來經(jīng)濟(jì)儲(chǔ)備專業(yè)人力梯隊(duì)
- 前10月我國家用電器制造行業(yè)增加值增長5.5%
- 礦石供應(yīng)再生變 錫價(jià)仍有上行空間
- 鋁土礦價(jià)格是否已見底?
- 浙江杭州銀齡教育更普惠
- 國家中小學(xué)智慧教育平臺(tái)開展特殊教育在線教研活動(dòng)
- 基本面改善 鉛價(jià)下行空間有限
- 美聯(lián)儲(chǔ)議息會(huì)議在即 滬金價(jià)格高位震蕩待破局


